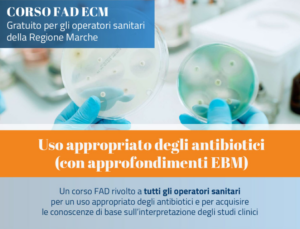

CAMBIAMENTI CLIMATICI. IMPATTO SULLA SALUTE GLOBALE (Tolentino,21/03/2026)
Evento organizzato dall’ Ordine dei Medici Chirurghi ed Odontoiatri di Macerata con il patrocinio del Comune di Tolentino, dell’ Università degli Studi di Macerata, l’
Dal Lun al Gio:
9 -13 | 16 - 18
Venerdi: 9 -13
Via Famiglia Palmieri, 6
62100 - Macerata

Evento organizzato dall’ Ordine dei Medici Chirurghi ed Odontoiatri di Macerata con il patrocinio del Comune di Tolentino, dell’ Università degli Studi di Macerata, l’

Torna finalmente disponibile “Fondamenti di telemedicina per il medico”, il corso fruibile gratuitamente tramite la piattaforma Tech2Doc, punto di riferimento per medici e odontoiatri italiani che vogliono
Il corso rientra nel progetto COSIsiFA – Cittadini e Operatori Sanitari sempre in-formati sul Farmaco Gratuito per gli operatori sanitari della Regione Marche Crediti ECM:

Il corso rientra nel progetto COSIsiFA – Cittadini e Operatori SanItari sempre in-formati sul Farmaco Gratuito per gli operatori sanitari della Regione Marche Crediti ECM:
Nelle prossime settimane di gennaio e febbraio 2026, sono state organizzate dal Dipartimento due giornate di formazione gratuita in aula sulla riforma in materia di

in questa sessione gli iscritti potranno iscriversi e fruire dei percorsi formativi a distanza sulla salute pubblica dell’Istituto Superiore di Sanità (ISS). EDUISS

in questa sessione gli iscritti potranno trovare tutti i corsi on-line organizzati dall’Ordine dei Medici e Odontoiatri di Macerata in collaborazione con la Federazione Nazionale Medici
Provider: B.E. BETA EVENTI SRL Segreteria organizzativa: 07331584336 Dal 26/02/2026 e 26/03/2026 – Treia e Macerata – Partecipazione gratuita – Crediti ECM:8 PROGRAMMA ALLEGATO AGENAS
Provider: TOP CONGRESS Segreteria organizzativa: cell. 3485463608 21/02/2025 – Sala convegni Fisiomed – Sforzacosta di Macerata – Partecipazione gratuita – Crediti ECM: 4 PROGRAMMA ALLEGATO
Provider: CONSORZIO MED3 Segreteria organizzativa: 0517190132 Dal 19/02/2026 al 19/11/2026 – Fondazione ANT Italia Onlus – Civitanova Marche – Partecipazione gratuita – Crediti ECM: 30
Provider: NICO SRL Segreteria organizzativa: tel. 0558797796 26/02/2025 – Hotel Cosmopolitan – Civitanova Marche – Partecipazione gratuita – Crediti ECM: 3 PROGRAMMA ALLEGATO AGENAS
Provider: WHITENING SRL Segreteria organizzativa: 0753/880441 Patrocinio dell’ Ordine dei Medici Chirurghi ed Odontoiatri di Macerata 28/02/2026 – EGO Hotel – Ancona – Partecipazione gratuita
Provider: PROMISE GROUP SRL Segreteria organizzativa: tel. 071202123 Patrocinio dell’ Ordine dei Medici Chirurghi ed Odontoiatri di Macerata 21/03/2026 – Hotel Horizon – Montegranaro –
Provider: ADVANCED SRL Segreteria organizzativa: 07155165 7/03/2026 – Aula didattica Mozzi Borgetti – Macerata – Partecipazione gratuita – Crediti ECM:7 PROGRAMMA ALLEGATO AGENAS LINK ISCRIZIONI
Provider: XENIA SAS DI MAZZA FRANCESCA & C. Segreteria organizzativa: 0984444890 13/03/2026 – Sala convegni fondazione Aron – Macerata – Partecipazione gratuita – Crediti ECM:
Provider: PROMISE GROUP SRL Segreteria organizzativa: 071202123 Patrocinio dell’ Ordine dei Medici Chirurghi ed Odontoiatri di Macerata 14/03/2026 – Domus San Giuliano – Macerata –
Provider: PROMISE GROUP SRL Segreteria organizzativa: 071/202123 Patrocinio dell’ Ordine dei Medici Chirurghi ed Odontoiatri di Macerata 27/03/2026 – Civitanova Marche – Partecipazione gratuita –
Provider: B.E. BETA EVENTI SRL Segreteria organizzativa: tel. 0712076468 Patrocinio dell’ Ordine dei Medici Chirurghi ed Odontoiatri di Macerata 11/04/2026 – Gran Sala Piero Cesanelli
Provider: FONDAZIONE FADOI Segreteria organizzativa: Tel. 3460393979 16/04/2026 – Università degli Studi di Camerino – Partecipazione gratuita – Crediti ECM: 7 PROGRAMMA ALLEGATO AGENAS
Provider: COLLAGE SPA Segreteria organizzativa: tel. 337/1655491 Dal 24/04/2026 al 12/06/2026 – Domus San Giuliano – Macerata – Partecipazione gratuita – Crediti ECM: 7.8 PROGRAMMA ALLEGATO
Provider: PLANIFY EVENTS Segreteria organizzativa: cell. 3332257069 Patrocinio dell’ Ordine dei Medici Chirurghi ed Odontoiatri di Macerata 9/05/2026 – Hotel Cosmopolitan di Civitanova Marche – Partecipazione
Provider: DYNAMICOM EDUCATION SRL Segreteria organizzativa: Tel. 0289693750 16/04/2026 – Teatro della Società Filarmonico drammatica di Macerata – Partecipazione gratuita – Crediti ECM: 3.9 PROGRAMMA